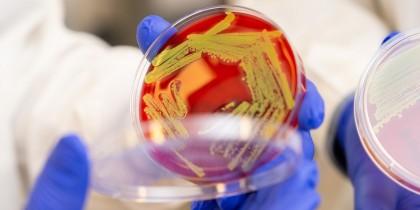

O descoperire inovatoare ar putea duce la un vaccin eficient pentru stafilococul auriu
©
Autor: Airinei Camelia
Un mecanism ocult al eșecurilor vaccinale
Multe studii preclinice pe È™oareci au indicat potenÈ›ialul unor vaccinuri anti-S. aureus, însă succesul obÈ›inut la animale nu s-a tradus în protecÈ›ie la om. Conform noilor date, expunerea precoce a oamenilor la S. aureus încă din copilărie modifică profund modul în care sistemul imunitar va reacÈ›iona ulterior la aceleaÈ™i antigene bacteriene. IniÈ›ial, sistemul imun „învățat” de S. aureus nu generează anticorpi eficienÈ›i. Ulterior, orice încercare de vaccinare activează acelaÈ™i tipar imun, ducând la producÈ›ia de anticorpi slăbiÈ›i È™i incapabili să elimine bacteria.Rolul celulelor B È™i al interleukinei-10 (IL-10)
Un prim studiu publicat în Journal of Clinical Investigation a analizat contribuÈ›ia celulelor B (principalele surse de anticorpi) în ineficienÈ›a răspunsului vaccinal. Cercetătorii au observat că, după o a doua întâlnire cu S. aureus, celulele B produc cantități mari de IL-10. Această citokină, odată prezentă în exces, determină o modificare a structurii anticorpilor prin adăugarea masivă de acid sialic în regiunea Fc. În mod normal, anticorpii ar trebui să se lege de bacterie È™i să declanÈ™eze reacÈ›ii celulare de eliminare, însă acest „decor” sialic le inactivează potenÈ›ialul protector. Rezultatul: anticorpii, deÈ™i prezenÈ›i, sunt nefuncÈ›ionali, iar vaccinul devine inutil.O descoperire cheie este că prin blocarea IL-10 în momentul vaccinării, anticorpii redevin eficienÈ›i. Astfel, un vaccin anti-S. aureus considerat eÈ™uat anterior la È™oareci deja expuÈ™i la această bacterie, funcÈ›ionează perfect când IL-10 este neutralizată.
Implicațiile pentru celulele T și citokina IL-17A
Un al doilea studiu, publicat în Nature Communications, s-a concentrat pe celulele T helper (CD4+), esenÈ›iale pentru coordonarea răspunsului imun celular. În condiÈ›ii normale, aceste celule secretă IL-17A, un factor important în lupta împotriva S. aureus. Dar, la indivizi cu expunere anterioară la bacterie, È™i aceste celule încep să producă IL-10 în exces, inhibând sinteza de IL-17A. Ca urmare, sistemul imun pierde un element-cheie în combaterea infecÈ›iei.Adăugarea unei componente adjuvante, CAF01, care stimulează robust răspunsul celulelor T, reuÈ™eÈ™te să contracareze efectul IL-10 È™i să restabilească nivelurile de IL-17A, transformând un vaccin anterior nefuncÈ›ional într-unul capabil să protejeze animalele pre-expuse la S. aureus.
Consecințe pentru dezvoltarea vaccinurilor umane
Aceste studii fac lumină într-un mister care a frânat progresul vaccinurilor anti-S. aureus timp de ani de zile. ObservaÈ›iile demonstrează că problema centrală nu constă în absenÈ›a È›intelor antigenice potrivite, ci în modul în care bacteria manipulează răspunsul imun în direcÈ›ia unei toleranÈ›e disfuncÈ›ionale. ÎnÈ›elegerea mecanismelor prin care IL-10 subminează atât funcÈ›ia anticorpilor cât È™i pe cea a celulelor T deschide calea către strategii noi:- Inhibarea IL-10 în timpul vaccinării: Prin blocarea IL-10, vaccinurile deja existente, dar nefuncÈ›ionale la oameni, ar putea deveni eficiente.
- CreÈ™terea IL-17A: Utilizarea de adjuvanÈ›i precum CAF01 poate spori răspunsul T helper È™i reinstala capacitatea sistemului imun de a produce IL-17A, critică în eliminarea S. aureus.
- Aplicabilitate extinsă: Fenomenul nu este probabil limitat la S. aureus. Bacteriile și paraziții care induc producerea de IL-10 (cum ar fi Clostridioides difficile sau agenții malariei) ar putea fi responsabili și de eșecurile altor vaccinuri. Neutralizarea IL-10 sau modificarea profilului citokinic ar putea restabili eficacitatea unor vaccinuri considerate fără succes.
Concluzii
Aceste descoperiri indică faptul că problema fundamentală a eÈ™ecului vaccinurilor anti-S. aureus la om nu este legată de absenÈ›a unei È›inte antigenice adecvate, ci de modul în care bacteria reuÈ™eÈ™te să „programeze” sistemul imun uman pentru a produce anticorpi È™i celule T ineficiente. Prin înÈ›elegerea È™i corectarea acestui mecanism - fie prin blocarea IL-10, fie prin utilizarea de adjuvanÈ›i specifici - vaccinurile pot fi revitalizate, nu doar împotriva S. aureus, ci È™i împotriva altor patogeni care utilizează strategii similare. Astfel, un obstacol major în controlul acestei bacterii ar putea fi în sfârÈ™it depășit.sursa: News Medical
foto: Culturi de Staphylococcus aureus. Kyle Dykes/UC San Diego Health Sciences.
Data actualizare: 18-12-2024 | creare: 18-12-2024 | Vizite: 382
Bibliografie
Breakthrough discovery could lead to effective vaccine for S. aureus, link: https://www.news-medical.net/news/20241216/Breakthrough-discovery-could-lead-to-effective-vaccine-for-S-aureus.aspx ©
Copyright ROmedic: Articolul se află sub protecția drepturilor de autor. Reproducerea, chiar și parțială, este interzisă!
Alte articole din aceeași secțiune:
Din Biblioteca medicală vă mai recomandăm:
Din Ghidul de sănătate v-ar putea interesa și:
Forumul ROmedic - întrebări și răspunsuri medicale:
Pe forum găsiți peste 500.000 de întrebări și răspunsuri despre boli sau alte subiecte medicale. Aveți o întrebare? Primiți răspunsuri gratuite de la medici.- Stafilococ auriu si probleme de rinichi?
- Circumcizie, stafilococ sau herpes genital
- Stafiloco, Candida.
- Tratarea stafilococului auriu in gat
- Tratament pentru Staphylococcus aureus
- Staphylococcus aureus
- Stafilococc aureus si cosurile
- Cancer ORL si stafilocc auriu
- Stafilococ auriu în gat.
- Stafilococ auriu +